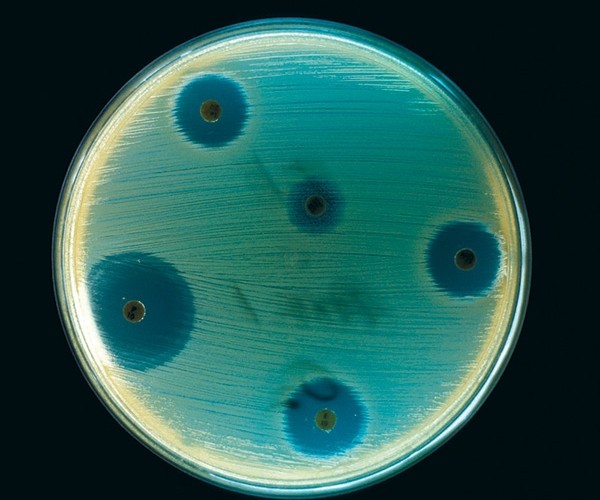

Ужас, но не ужас-ужас
Грозят ли человечеству смертоносные инфекции, если антибиотики помогают все хуже

Получить ранение или воспаление легких еще сто лет назад означало оказаться у края гробовой доски — инфекции в считаные дни уносили в могилу столько жизней, что современному человеку даже не вообразить. Во многом благодаря открытию антибиотиков население Земли за ХХ век увеличилось более чем в четыре раза. Казалось, мы нашли панацею от неизлечимых инфекций. Но эволюция не стоит на месте, а бактерии тоже хотят жить — они мутируют в новые штаммы, не поддающиеся лечению известными антибиотиками. Чтобы узнать, угрожает ли человечеству гибель от новых эпидемий и как теперь бороться с ними, корреспондент «РР» обратилась к профессору Константину Северинову
Проклятье цивилизованного мира
— По прогнозу Всемирной организации здравоохранения, в 2050 году из-за причин, связанных с лекарственной устойчивостью, будут погибать около 10 миллионов человек в год, что численно сопоставимо с нынешней смертностью от рака.
— Мне кажется, цифра сильно занижена, — с недоверием комментирует эту статистику Константин Северинов. — Даже сейчас количество смертей, так или иначе связанных с микробами, значительно больше. В конечном счете мы все погибаем от инфекций, потому что баланс между нами и микробами, населяющими нас, нарушается. Большинство людей с диагнозом «СПИД», «лейкемия» или «муковисцидоз» умирают не от этих болезней, а от бактериальных инфекций, развивающихся на фоне вызванного заболеванием (или его лечением) ослабления иммунитета. Многие такие инфекции вызваны бактериями, устойчивыми к антибиотикам.
— Антибиотики — это вещества, с помощью которых бактерии воюют между собой за ресурсы?
— Частью да. Но вообще этот термин очень широкий. Как ясно из названия, антибиотики направлены против некоей жизни. Например, онкологи называют антибиотиками лекарства, которые используются для ограничения роста раковых клеток, но многие из этих веществ никакого эффекта на бактерии не оказывают. С другой стороны, многие антибиотики — это действительно вещества, которые выделяют одни бактерии, чтобы ограничить рост других. Есть и полностью созданные в лаборатории препараты, не встречающиеся в природе — например, широко используемый ципрофлоксацин. Существуют и полусинтетические антибиотики: основой берутся вещества, выделяемые бактериями или микроскопическими грибами, а потом они модифицируются в лаборатории.
— Бактерии становятся все более агрессивными и устойчивыми к антибиотикам?
— Люди умирают не потому, что бактерии стали агрессивнее, а потому, что препараты не работают. С точки зрения бактерии, антибиотикоустойчивость — это добавочная вещь, которая в нормальных условиях не нужна и даже обременительна для ее обладателя. Но повсеместное использование антибиотиков привело, строго в соответствии с описанным Дарвином механизмом эволюции, к отбору, в ходе которого произошла постепенная замена чувствительной микрофлоры на более приспособленную, то есть устойчивую к антибиотикам. Иначе и быть не могло.
— Так что же, антибиотики совсем перестают работать?
— Пока лишь в очень-очень малом числе случаев. В общем и целом они работают — или, вернее, удается подобрать такой антибиотик, который работает. Что почти удивительно, учитывая их очень широкое и часто неразборчивое применение. Есть причины для озабоченности, но пока антибиотики не утратили свою силу. Это как в старом анекдоте: ужас, конечно, но не ужас-ужас-ужас. Если бы не было работающих антибиотиков, то ситуация в медицине была бы совсем не такой, как сейчас. Любому человеку в больнице после операции ставят капельницу, в которой находится антибиотик — ровно для того, чтобы предотвратить рост бактерий, который мог бы привести к смерти пациента.
— Но в СМИ масса сообщений о том, что мы проигрываем в этой борьбе.
— На мой взгляд, это не вполне здоровая и даже вредная паника. Всего лишь сто лет назад все было гораздо страшнее: антибиотики еще не открыли, была чудовищная детская смертность, как и смертность раненых на полях сражений. В столице Российской империи в конце XIX века умер от холеры Петр Ильич Чайковский — наше все. Сейчас мы от холеры в общем и целом не умираем. И дети массово не умирают — во многом благодаря вакцинации и антибиотикам.
Флеминг, открывший пенициллин в самом конце 20-х годов прошлого века, уже к концу 1930-х годов, еще до начала широкого применения пенициллина для лечения людей, предсказывал появление и распространение устойчивости. И в начале 1950-х годов она появилась — сначала в госпиталях, потом и у микробов из окружающей среды. Сейчас у врачей есть довольно обширная палитра антибиотиков, действующих по-разному на разные клетки. Но в последние несколько десятков лет новых антибиотиков в медицинскую практику вводилось мало, так что появление микробов, устойчивых к уже используемым антибиотикам, — просто вопрос времени.
Кстати, сводить снижение смертности только к антибиотикам неправильно, хотя они, конечно, очень сильно помогли. В начале XX века смертность стала понижаться еще и потому, что распространение централизованного водоснабжения, отведение отходов от городов, общее повышение уровня гигиены и санитарии снизили вероятность заражения. Кроме того, эпидемия туберкулеза, так называемой чахотки, которая была проклятьем цивилизованного мира, резко пошла на спад после того, как лошадей перестали держать в городах. Возможно, лошади или навоз способствовали распространению инфекции. Хотя нельзя не отметить, что туберкулез, наряду с малярией, и сейчас является одной из основных причин смертности на планете.
Денег нет, но вы держитесь
— Почему новые антибиотики появляются все реже?
— В былые времена разработка новых антибиотиков была делом весьма дешевым, в частности потому, что зарегулированность медицинского бизнеса была гораздо меньше. Очень поспособствовала этому Вторая мировая война, потому что тогда не до регуляции было. Я в Америке работаю в Институте Ваксмана, построенном на деньги, полученные за патент на антибиотик стрептомицин. Зельман Ваксман за открытие стрептомицина получил Нобелевскую премию. Препарат позволял вылечиваться от туберкулеза, но при ненадлежащей очистке и неправильном использовании приводил к глухоте у пациентов. Это плохо, но все-таки лучше, чем умереть от туберкулеза.

Многие лекарства, разработанные в то время, сегодня не прошли бы на рынок — бутылочное горлышко, создаваемое нынешними правилами, гораздо уже. Проведение всех доклинических и клинических испытаний, необходимых в наше время для доказательства безопасности и эффективности препарата, обходится очень дорого. И тут вступают в силу экономические соображения, потому что антибиотики, как правило, достаточно дешевы, а следовательно, производить их не очень выгодно. Что еще хуже, большинство людей, страдающих от бактериальных инфекций, как правило, не очень платежеспособны.
— Даже на самые дешевые антибиотики нет денег?
— Про это я не знаю, но, например, в Бангладеш, одной из беднейших стран мира, люди продолжают умирать от холеры. Сложная ситуация со множественной устойчивостью в тюрьмах, в частности российских. Прежде всего, это касается микробов, которые вызывают туберкулез. Это серьезная проблема. Страны Западной Европы хотели бы сделать подобие санитарного кордона, чтобы «выведенные» у нас штаммы не просочились к ним. Потому что лечить болезнь, вызванную такими штаммами, тяжело и дорого. Это болезнь бедных, и занимаются ею часто филантропические организации — например, фонд Билла и Мелинды Гейтс. Разрабатывать лекарства от рака или от лишнего веса гораздо выгоднее, потому что пациенты богаче, а лечение — продолжительней. С инсулином все еще «лучше», потому что больные диабетом неизлечимы и колоть препарат им придется всю жизнь. Пациент же, который имеет острую инфекцию, вызванную бактериальным патогеном, либо умрет, либо быстро вылечится под действием антибиотика — да еще и не факт, что заплатит.
Редкие, но громкие смерти
— Есть еще зоны повышенного риска, кроме тюрем?
— Госпитали во всем мире являются проблемными: ведь это места, где концентрируется много больных людей. И раз антибиотики там есть всегда, то со временем бактерии становятся к ним устойчивыми. Поэтому в любом приличном госпитале есть микробиологические лаборатории. Там анализируют возбудителей, полученных от пациентов, и проверяют на устойчивость к тому или иному антибиотику. Но эти проверки, как правило, достаточно длительны. Пациент может умереть до того, как вы узнаете, чем его стоило бы лечить. Иногда люди подхватывают внутригоспитальную инфекцию, которую вылечить практически невозможно.
— Насколько распространены такие случаи?
— В целом подобных случаев немного. В Москве каждый день умирают тысячи человек. Многие из них — от инфекций, но это не вызывает шумихи в прессе. Однако стоит любопытной семидесятилетней старушке съездить в Индию, подхватить там что-то и попасть в госпиталь в Небраске, где ее ничем не могут пролечить и она умирает, как эта новость тут же появляется во всех СМИ! Такой эпизод интересней как новостной повод, но общую картину, слава богу, он не отражает.
Мы — куски мяса для бактерий
— Значит, в целом прогноз выживаемости у человечества хороший?
— Все может развиться и по плохому сценарию. Но предсказать, где, как и когда именно станет плохо, невозможно.
Хорошо было бы иметь миллион банок с разными антибиотиками для разных бактерий, чтобы их можно было выбирать как блюда из меню в ресторане. Но произвести их заранее, как запас для будущих экстренных ситуаций, невозможно: ведь неизвестно, как именно бактерии будут мутировать под действием нынешних препаратов. Вопрос даже не в том, возникнет ли устойчивость при использовании конкретного антибиотика, а в том, с какой скоростью она распространится, станет повсеместной. Задача уничтожения всех бактерий, которые вызывают какую-то дурную болезнь, вообще не может быть решена — нужно смириться с тем, что бактерии вокруг и внутри нас будут всегда.

С точки зрения бактерий, мы просто куски мяса, на которых они живут. В нашем кишечнике, в носоглотке, на коже их огромное множество. Некоторые из этих бактерий патогенны, большинство в нормальных условиях — нет. Но как только возникнут подходящие условия, и те и другие могут нас укокошить. Ведь когда мы умираем, нас поедают не черви, а наши собственные бактерии — при этом разные их типы сменяют друг друга, как танцоры в балете, и в результате этого наши тела довольно быстро разлагаются. Сейчас исследования «некробиома» становятся модными: например, по преобладающим в разлагающемся трупе бактериям можно довольно точно определить, когда человек умер.
— А можно понять по бактериям, когда человек еще жив, но уже вот-вот отойдет в мир иной?
— Это видно и невооруженным глазом, зовут же некоторые в этот момент священника для отпущения грехов. Сейчас очень модно заниматься живущими в нашем кишечнике бактериями, пересадкой кала и так далее. Говорить об эффективности таких процедур, наверное, еще рано. Бактерии, безусловно, влияют на наше здоровье. И не только на болезни, но и на поведение, самочувствие и многое другое. А вот как это происходит, на текущий момент непонятно. Наука, которая может это как-то изучать или хотя бы документировать, называется метагеномикой. Ей нет и десяти лет, пока идет просто накопление материала. Но совершенно ясно, что мы не можем жить без наших микробов. Зато они без нас могут.
— Как бактерии вырабатывают устойчивость к антибиотикам?
— Устойчивость существовала всегда, просто она встречалась реже. Есть микробы, которые обладают способностью производить антибиотики. А есть те, которые не подвержены их воздействию — обладатели генов устойчивости. Эти же гены, естественно, есть и у самих бактерий-продуцентов, иначе как бы они существовали? Многие гены устойчивости относятся к классу прыгающих генов, они могут передаваться от одного микроорганизма другому. Вообще так называемый горизонтальный перенос, обмен генами между бактериями разных видов — норма жизни для микробов.
С существами, подобными нам, этого не происходит. Представьте себе, что есть набор генов, ответственный за хобот у слона. У нас нет возможности естественным образом интегрировать эти гены в нашу собственную ДНК и сделать так, чтобы они правильным образом работали. Потому и хобота у нас нет, как бы ни хотелось! А у бактерий передача гена или групп генов другому виду — обычное дело. И обмениваются генами виды бактерий, которые отстоят друг от друга гораздо дальше, чем слоны и мы с вами. Среди генов, которые другим бактериям имеет смысл приобрести, находятся и гены устойчивости к антибиотикам. При повышении концентрации конкретного антибиотика в окружающей среде бактерия, случайно получившая ген устойчивости к нему, получает гигантское преимущество: все ее родственники погибнут, а она размножится и ее потомство будет оставаться устойчивым, пока антибиотик присутствует в окружающей среде.
— Получается, «гонка вооружений» между нами и бактериями неизбежно будет продолжаться?
Очень важно понимать, что бактерии ни в коем случае не находятся с нами в состоянии войны. Они не хотят нас захватить и насолить нам. Если антибиотики убрать, то несчастные микробы, обладающие генами устойчивости, скорее всего, погибнут. Вернее, окажутся вытеснены вариантами, которые гены устойчивости либо случайно потеряли, либо никогда их не имели. Потому что в отсутствие антибиотика гены устойчивости к нему — как чемодан без ручки. Бактерии без этих генов будут размножаться быстрее. На этих соображениях построена одна из идей о том, как можно попытаться контролировать проблему устойчивости к антибиотикам — посредством ротации препаратов, убирая некоторые из них на полку на достаточно долгие периоды времени. В результате устойчивые бактерии должны прийти «в норму», потерять гены устойчивости, которые им стали не нужны. Но для того, чтобы такая стратегия работала, надо договориться со всеми, кто тот или иной антибиотик применяет, во всем мире. Очевидно, что это малореально. Так что проблема не в микробах, а в людях.
Антибиотики в нашей еде
— Применение антибиотиков в сельском хозяйстве дает слишком большой рост доходности?
— Да. Потому что, во-первых, снижается заболеваемость птиц и скота. А производители, естественно, очень трепетно относятся к своим зверушкам, потому что делают на них деньги. Кроме того, многие антибиотики стимулируют рост; причины этого не до конца ясны. Поэтому использование антибиотиков в сельском хозяйстве целесообразно и, главное, выгодно. А это приводит пусть к незначительному, но повышению концентрации антибиотиков во внешней среде в глобальном масштабе. Что в свою очередь повышает уровень устойчивости у всех бактерий.
— Правда ли, что вместе с мясом мы поглощаем антибиотики и наша микрофлора приобретает устойчивость к ним?
— Нужны хорошие данные, которые могли бы это подтвердить или опровергнуть, а они пока еще только собираются, хотя есть некоторые исследования, которые указывают, что так может быть. Использование антибиотиков может приводить не столько к появлению устойчивости у каких-то конкретных вредных бактерий, сколько к общему увеличению концентрации генов устойчивости в сообществе бактерий, обитающих в том или ином месте. Сотрудники Смоленской медицинской академии нашли корреляции между уровнем устойчивости к конкретным антибиотикам и количеством их продаж в определенном регионе. Чем больше продажи, тем, очевидно, больше люди используют антибиотики. Даже забавно — потребляя антибиотики, мы вроде бы убиваем патогенные бактерии, но в то же время делаем их более опасными. Всегда остается небольшое количество устойчивых к данному антибиотику бактерий, которые потом мгновенно размножаются и занимают место, освобожденное погибшими чувствительными микробами.

— Но без лечения антибиотиками люди бы умирали…
— Да, это так. Между прочим, с точки зрения эволюции человека как вида, возможно, было бы лучше, чтобы заболевшие бактериальными инфекциями погибали без всяких антибиотиков. Прогресс медицины и здравоохранения в ХХ веке привел к тому, что мы в значительной степени вышли из-под действия естественного отбора, который сделал нас тем, кто мы есть. Отсутствие отбора приводит к накоплению вредных генетических мутаций в человеческой популяции, которые однажды могут сыграть с нами злую шутку. Возможно, мы вымрем не от инфекций, а именно из-за того, что сейчас от них не умираем, и наши дети накапливают все больше и больше вредных мутаций, а затем передают их своим детям.
Повторюсь, пока что нет поводов для паники, хотя исковерканные судьбы, безусловно, есть, и умирающие в госпиталях люди, которых нельзя вылечить из-за того, что на них не действуют антибиотики, тоже есть. И если попытаться сделать прогноз, основывающийся на тенденциях последних 40–50 лет, можно уверенно предсказать, что проблема множественной лекарственной устойчивости бактерий будет усугубляться.
Панацея лежит под ногами
— Как сейчас обстоят дела с разработкой новых антибиотиков?
— Принято говорить, что этим мало занимаются. На самом деле есть много научных групп, которые ведут поиск новых антибактериальных веществ. Но антибактериальных веществ известно очень много, десятки тысяч. А практически применяемых антибиотиков всего около пятидесяти. То есть подавляющее большинство антибактериальных веществ не становится «хитом», не попадает в аптеки. Происходит это по ряду причин: есть побочные эффекты, очень дорого производить, невозможно произвести много вещества, оно нестабильно...
— Как ищут новые антимикробные лекарства?
— Понятно, что надо искать такие препараты, которые не похожи ни на один из тех, которые мы сейчас используем. Микробы существуют четыре миллиарда лет. За это время они стали очень разнообразными. Реальное биологическое разнообразие фармакологически активных веществ находится не в каких-нибудь лесах Амазонки, а в генах микробов, неисчислимые количества которых лежат под нашими ногами.
Стандартный процесс выделения антибиотиков основан на наблюдении за некоей бактерией, растущей у вас в чашке Петри со специальной питательной средой. Вы смотрите, будет ли вокруг колонии, образованной в результате роста этой бактерии, подавляться рост другой интересующей вас бактерии, например возбудителя какого-то заболевания. Если рост подавлен, значит, колония выделяет вещество-ингибитор; можно попробовать его выделить и изучить.
Но проблема оказалась вот в чем: чтобы таким способом выделять препараты, нужно как минимум, чтобы ваша бактерия — производитель антибиотика в чашке Петри росла. А лет двадцать назад стало понятно, что абсолютное большинство бактерий расти на наших чашках не желает! Им не нравится пища, которую мы им предлагаем. Считается, что 99,99% бактерий, живущих на Земле, не поддается культивированию в лабораториях — это своего рода «темная материя» микробов. Наверное, среди этих неизвестных микробов есть и такие, которые производят принципиально новые антибиотики, совершенно не похожие на те, что у нас уже есть.
— И с этим ничего нельзя сделать?
— Можно. Сейчас развитие геномных технологий позволяет не культивировать бактерии, а напрямую читать их гены и затем методами биоинформатики на компьютерах предсказывать последовательности ДНК, гены, которые могли бы кодировать новые антибиотики. На основе таких предсказаний можно создавать генномодифицированные микробы, пресловутые ГМО, не встречающиеся в природе. Для этого предсказанные гены синтезируют химическими методами на специальных машинах и подсаживают их в какой-нибудь хорошо известный модельный микроорганизм, например в кишечную палочку, которая хорошо плодится в лаборатории. При этом мы надеемся, что подсаженные гены заработают на новом месте и наша кишечная полочка станет производителем нового перспективного вещества. Кое-что находят так иногда, но очевидно, что поиск сейчас идет далеко не в полную силу. Хотя если уж совсем припрет, думаю, новые антибиотики появятся.
Вирусы против микробов
— Технология редактирования генома CRISPR, с которой связано множество прорывов последнего времени, поможет нам в борьбе?
— CRISPR-редакторы — это такие молекулярные ножницы, которые могут привести к разрыву практически в любом заранее выбранном участке ДНК. Можно придумать систему, когда эти ножницы будут вырезать из ДНК бактерий гены устойчивости к антибиотикам. После обработки такими ножницами все бактерии теоретически должны снова стать чувствительными к антибиотикам. Можно попытаться сыграть с бактериями в эволюционную игру: мы начинаем применять антибиотик, они получают устойчивость к нему, но с помощью CRISPR мы ее отнимаем, чтобы опять использовать антибиотик.
— Могут бактерии потом как-то ответить и на это?
— Они точно ответят. Вопрос ведь не в том, что мы умнее. Тут как у Блока: «Мильоны — вас. Нас — тьмы, и тьмы, и тьмы...». Их количество зашкаливает. Они мутируют, изо всех сил пытаются выжить, как и мы, впрочем. Поэтому, когда мы им преподносим какую-нибудь гадость, они обязательно найдут чем ответить: они очень приспосабливаемые и существуют на Земле очень давно.

— Могут ли бактериофаги стать нашим следующим аргументом?
— Бактериофаги — это вирусы, способные уничтожать бактерии. По современным оценкам, на каждую бактериальную клетку приходится около десяти бактериофагов. Один бактериофаг может убить бактерию за десять-пятнадцать минут и произвести сто новых бактериофагов. Казалось бы, все бактерии давно должны были быть уничтожены, но этого, очевидно, не происходит. Бактерии выживают благодаря специальным девайсам. В частности, CRISPR — это ведь их изобретение для борьбы с бактериофагами, люди просто недавно стали использовать его в своих целях. Бактериофаги отвечают своими девайсами — у них есть анти-CRISPR. Это настоящая гонка вооружений без конца.
— Правда, что от бактериофагов мало побочных эффектов и их можно быстро научить «есть» нужные бактерии?
— Большинство заявлений о преимуществах бактериофагов над антибиотиками родом из Советского Союза и стран тогдашнего Восточного блока. В России многие любят повторять это и сейчас — в основном по недомыслию и из ностальгии по автохтонной советской науке. На самом деле с ними целая масса проблем, о которых никто не говорит и которые серьезно не изучались. Так, антибиотики обычно не вызывают иммунного ответа, а бактериофаги гарантированно его вызовут, что резко ограничит возможности их применения. Бактериофаги крайне изменчивы, вследствие чего их применение ненадежно. Одно из достоинств бактериофагов — их способность, в отличие от антибиотиков, убивать бактерии только одного вида. Но это же и их недостаток. Бактерии очень изменчивы, и оказывается, что вам надо иметь бактериофаги на каждый штамм, встречающийся в том или ином районе, или даже подбирать специальных фагов для каждого конкретного пациента. Понятно, что такая «персональная медицина» крайне неэффективна. Антибиотики в этом отношении, по крайней мере сейчас, прекрасны: в Америке, России или Китае проглотил таблетку — и, скорее всего, она сработает. Пока антибиотики в подавляющем большинстве случаев работают и механизм их действия на бактерии понятен и хорошо изучен, а лечение бактериофагами в основном подкрепляется утверждениями вроде «мой родственник принимал и выздоровел». Серьезных перспектив у них немного.
— Сейчас отовсюду слышны призывы укреплять иммунитет. Иммунотерапия — действенный метод?
— Я не специалист в этой области, но мне кажется, эти призывы в основном от жуликов, как и в случае со всякими биодобавками. Есть правильное, но слишком общее и оттого довольно бессодержательное соображение, что всегда имеется некий баланс — наш организм находится в равновесии с микробчиками, которые в нем живут. Нарушение этого равновесия может означать болезнь и всякие неприятности. Что в общем вполне логично. А потом делается вывод, что, изменяя иммунный статус организма, можно повлиять на заболевание. Но на самом деле мы так мало понимаем, каким образом работает наша иммунная система, что попытки направленного воздействия на нее могут дать непредсказуемый эффект! Думаю, ни один из людей, болтающих сегодня о пользе иммуномодуляторов, не сможет объяснить вам, как они работают — разве только на уровне общих слов.
Фотографии: Pixabay; Brattarb/Wikimedia Commons; phil.cdc.gov; Science Museum London (2); Roger Higgins/Library of congress
Хочешь стать одним из более 100 000 пользователей, кто регулярно использует kiozk для получения новых знаний?
Не упусти главного с нашим telegram-каналом: https://kiozk.ru/s/voyrl